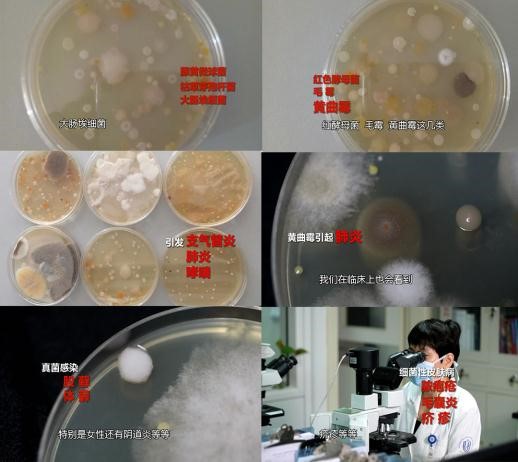

人们每天平均大约有80%以上的时间正在室内渡过。特别是婴长儿,体弱、机体抵当力较低,户外机遇更少,因而,室内空气质量的黑白取他们的关系尤为主要。最常见的室内污染就是甲醛,苯系物,氨气等。室内空气污染会对儿童形成以下三大体挟:诱发儿童的血液性疾病、添加儿童哮喘病的发病率、影响儿童的身高和智力健康发育。现实惹人深思!
做为家长正在扫除的时候都有个习惯,将地面擦清洁就感觉是实正的清洁!其实否则!家庭室内空气污染次要有气体污染和微生物污染。然而,微生物污染的祸首也恰是由于室内潮湿。看似平安干净的家中,实则躲藏着上亿细菌,以家中细菌温床的卫生间为例,单是每冲一次马桶,每立方米空气中就会添加1400个细菌和3600个病毒,大肠杆菌、藤黄微球菌、黄曲霉这些无害微生物以至会被扩散至空中,逗留数小时,对儿童以至是身体健康形成极大体挟。

由于一个父亲的爱而起头……中国浴霸行业创始者、集成吊顶行业带领者的奥普正在健康空气大款式的全新计谋下,力推新风取暖这一焦点产物,努力于给每一位准妈妈和可爱的宝宝一个平安舒服的糊口情况。新风取暖不只能够全域复式加热,还能够实现99%深度杀菌,输送室外的新颖空气,正在室内即便不开窗也能成功通风。
(以上内容来源如无标示深港网皆为本网站转自其它媒体,相关信息仅为传递更多信息之目的,不代表本网观点,亦不代表本网站赞同其观点或证实其内容的真实性。如有侵权,请来信告知,本站不负任何法律责任。)
